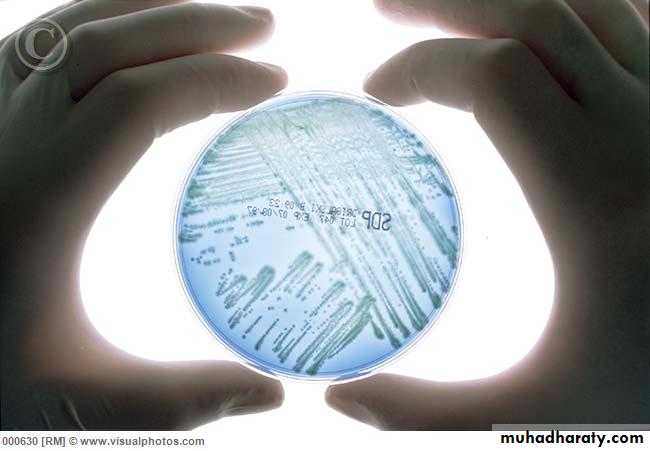
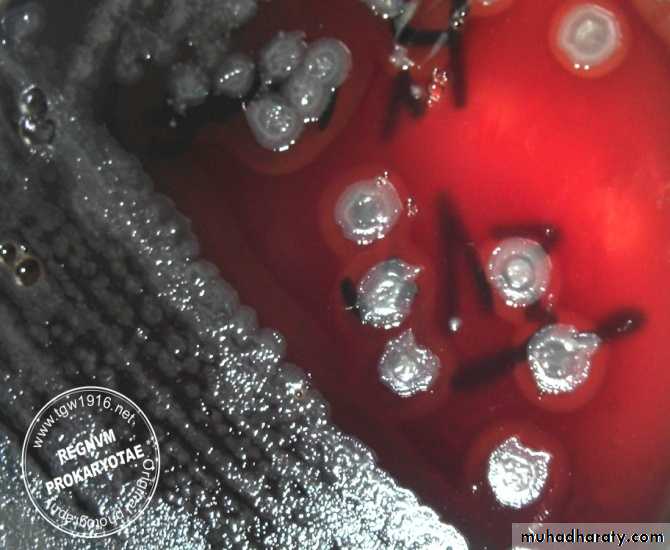
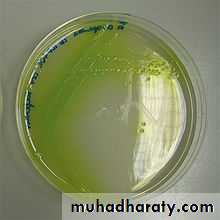
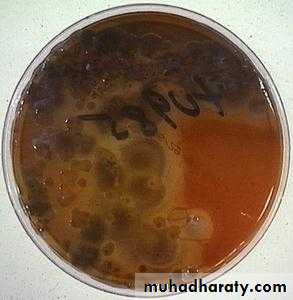
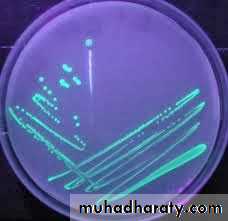
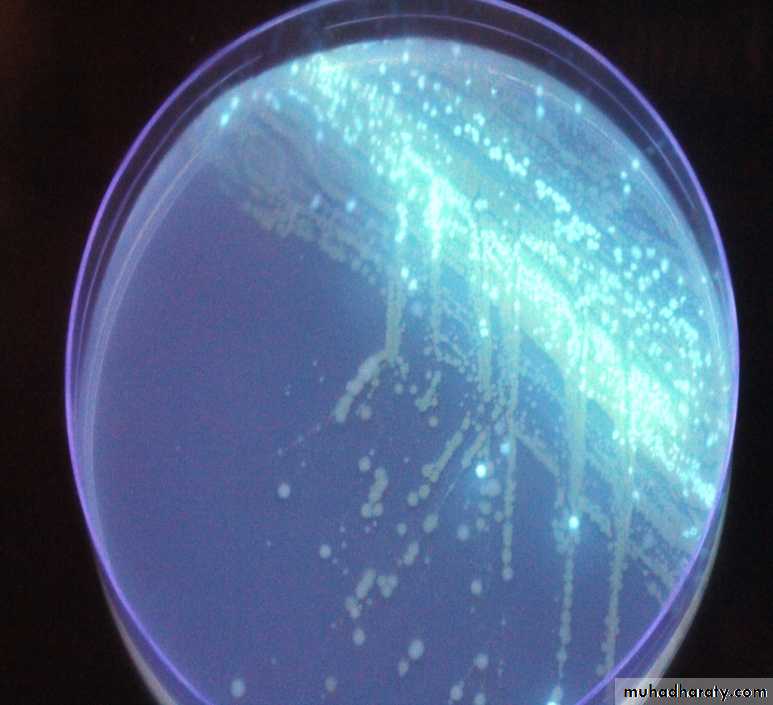
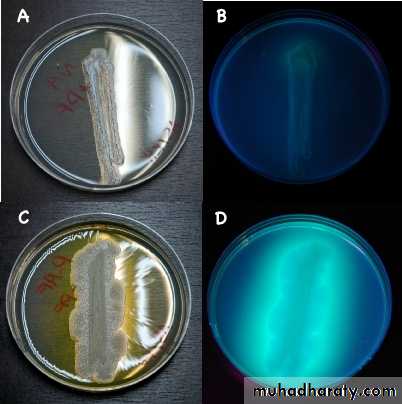

1
Pseudomonas
د.وليد خالد سعدون
2• There are many species of Genus Pseudomonas , the most important species in human being is Pseudomonas aeroginosa
• Genus Pseudomonas
• A large group of Gram negative bacilli that is distinct from family Enterobacteriaceae by being oxidase positive. They are non-fermentative for glucose and lactose but they are oxidative for them so they require O2 for their utilization, that is why they are obligatory aerobic.
3
They are found in nature in moist environments like water, soil, and in the hospitals including operative theatres. Pseudomonas are motile by polar flagella
4
• Motility of organism
5
Pseudomonas aeroginosa
• It is one of the most important and frequent species encountered from the clinical specimens and associated with many human infections, also it is very important in causing nosocomial infections being responsible for about 25% of these infections. Pseudomonas aeroginosa are dangerous microorganism as they are resistant to many antibiotics.
Cultural characters:-
-Obligatory aerobes that can grow on different culture media like nutrient agar, blood agar , chocolate agar and others. The growth can occur at a wide range of temperatures (6-42 C) with the optimum temperature of 37 C.-They form smooth, flat and large colonies with rounded or irregular edges with a fluorescent color, sweet odor, and B-hemolysis on blood agar.
7
The most distinguishing feature of Pseudomonas aeroginosa is the formation of diffusible pigmentation on nutrient agar .
There are 4 types of pigments produced :
1-Pyocyanin (bluish pigment) ; 2-Pyoverdin (greenish pigment);
3-pyorubin (reddish pigment ) ; 4-pyomelanin (black pigment)
8
Biochemical reactions
Catalase and oxidase tests are positive
Non fermentative for CHO
Glucose is utilized aerobically by oxidationIndole, MR ,VP and H2S tests are negative. Citrate utilization test is positive .
IMViC reaction is (-,-,-,+)
Oxidative fermentative test is O+ve/F-ve
9
Oxidative Fermentative (OF) test:-
-In this test we use two tubes of semisolid media that contain:
1- Low concentration of agar agar
2- High concentration of CHO
3- Bromothymol blue ( pH indicator which is normally green in color and becomes yellow in acidic pH) .
The two tubes are inoculated with the m.o. , then the first tube is covered with the mineral oil ( to prevent O2 from being in contact with the media) and the other tube is left opened.
10
11
-Then after 24-48 hours there will be oxidation of CHO in the opened tube ( as Pseudomonas aeroginosa is oxidative) changing the color of bromthymol blue from green to yellow, while the covered tube will remain green because the m.o. is not fermentative.
12
Also in this test the motility could be seen when the motile m.o. produce tree like appearance mainly toward the top of the tube ( aerobic m.o.)
Pathogenesis and Immunity
-This microorganism is widely distributed in nature and is commonly present in moist environments and in hospitals. It is pathogenic only when introduced into areas devoid of normal defenses, e.g.,1. Disruption of mucous membrane and skin.
2. Usage of intravenous or urinary catheters.
3. Neutropenia (as in cancer therapy).
Factors of pathogenicity of P. aeroginosa
1- Enzymes : Pseudomonas aeroginosa have 2 proteases that can cause skin haemorrhage and corneal destruction2- Exotoxins : A, B and C
3- Enterotoxins : Similar to enteroetoxins of E.coli causing diarrhea4- Haemolysins : 2 types responsible for the B-hemolysis on blood agar
15
5- Pigments : Specially pyocyanin which can affect O2 uptake by tissues and cells including leukocytes
6- Pilli and flagella : For the attachment ,resist phagocytosis and motility
16
Septicemia
CNS infections
Keratitis and corneal Ulceration
Malignant otitis Externa
Endocarditis
Respiratory infections in patients with cystic fibrosis
Urinary tract infections
Skin and nail diseases: Pseudomonas Folliculitis
Nosocomial infections
Diseases caused by Pseudomonas
17
Skin and nail diseases :
Pseudomonas FolliculitisPseudomonas Keratitis and Corneal Ulceration
Malignant Otitis Externa
Endocarditis
18Infection of Equipment's
Respirators
Endotracheal tubes can be Infected
All equipment's have to be sterilized
19
Identification of P. aeruginosa is usually based on:
1-Oxidase test : positive
2-Colonial morphology: smooth, flat and large colonies with rounded or irregular edges.
3- B-hemolysis on blood agar.
4-Growth at 42 oC .
5-The presence of characteristic pigments and sweet odor which is the most acceptable odor of the microorganisms ( some times described as a grape like odor) .
• Diagnosis of P.aeroginosa infection
20
6-Fluorescence under ultraviolet light is helpful in early identification of P. aeruginosa colonies. Fluorescence is also used to suggest the presence of P. aeruginosa in wounds.
21
22
Treating pseudomonas infections
The main problem is the antimicrobial resistance of P. aerogenosa. Many strains are sensitive to new penicillins, carbapenems and new fluoroquinolones. Antibiotic sensitivity test is required.
• The combination of gentamicin and carbenicillin is frequently used to treat severe Pseudomonas infections. Several types of vaccines are being tested, but none is currently available for general use.